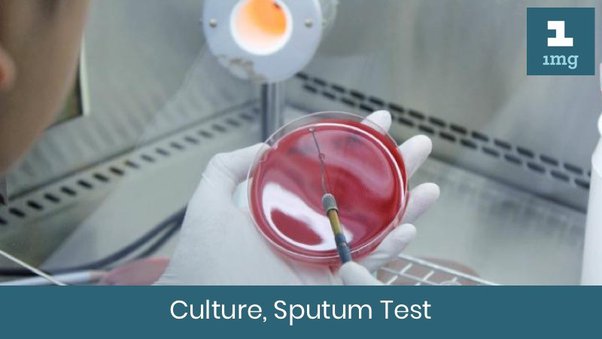

Culture and Sensitivity (Sputum)
4.6 (5 reviews)The Sputum Culture & Sensitivity test identifies bacteria causing respiratory infections and determines the most effective antibiotics.
Test Details
Also Known As
Sputum Culture Test, Sputum Culture & Antibiotic Sensitivity, Respiratory Culture Test, Sputum C/S Test, Lower Respiratory Tract Culture
Sample Type
Sputum
Gender
Male, Female
Age Group
All Ages
Categories
Pathology
Test Code
Sputum
A sputum culture and sensitivity test is a laboratory test that analyzes sputum (mucus coughed up from the lower airways) to identify any bacteria present and determine which antibiotics are effective against them. This helps doctors diagnose and treat respiratory infections more effectively.
If the sputum sample is abnormal, the results are called "positive." Identifying bacteria, fungi, or viruses in the sputum may help diagnose the cause of: Bronchitis (swelling and inflammation in the main passages that carry air to the lungs) Lung abscess (collection of pus in the lung) Pneumonia.
One of the best ways to diagnose TB is through a sputum culture. A sputum culture is a test to find germs (such as TB bacteria) that can cause an infection. A sample of sputum is added to a substance that promotes the growth of bacteria. If no bacteria grow, the culture is negative.
Recommended Tests

₹69.00 ₹200.00

₹69.00 ₹200.00

₹399.00 ₹800.00

₹299.00 ₹400.00

₹299.00 ₹600.00

₹399.00 ₹800.00

₹79.00 ₹200.00

₹1350.00 ₹2500.00

₹699.00 ₹1500.00